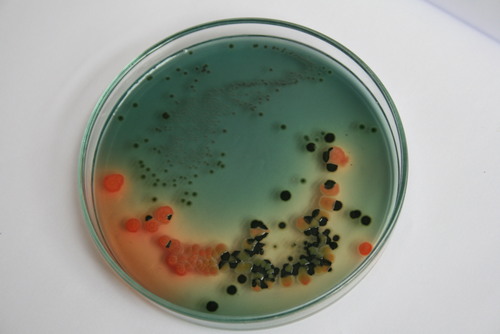

- Tradeindia
- Lab Chemicals & Supplies
- Culture Media
Culture Media
(167 products)Yeast Extract Powder - Amino Acids & Coenzymes, Food Grade, pH 5.5-6.5 | Clear Solution, Rich in Water Soluble Vitamins, Low Moisture Content
Price: 485 INR/Kilograms
MOQ25 Kilograms/Kilograms
Loss on Dryingnmt 7. 00% as estimated by aoac method
TasteOdorless
Appearancehaving characteristic yeast odour but not pungent
Assay3. 00 to 10. 00 % w/w as estimated by kjeldahlaEURtms method.
StorageKeep away from moisture
Physical FormPowder
New Alliance Fine Chem Private Limited
Mumbai
Super Bonanza
Trusted Seller
Super Premium16 Years
Fraser Broth Base - Packaging Type: Bottle Packing
Price: 9000 INR/Kilograms
MOQ2 Gram/Grams
Size500 g
Shelf Life12 Month Months
Physical StatePowder
Packaging Typebottle packing
Ph Level7.9 +-0.2
PurityHigh
Non Pyrogenic Cell Culture Dish With Flat Transparent Surface Application: Commercial
Product TypeCell Culture Dish
UsageLab
ColorTransparent
SizeDifferent Size Available
MaterialPlastic
ApplicationCommercial
Coarse Bubble Disc Diffuser - Efficiency (%): 98%
Price: 140.00 INR/Piece
MOQ100 Piece/Pieces
WarrantyYes
FeatureDurable, Non-corrosive, Specifically designed
Recycle Rate100%
Efficiency (%)98%
Usage & ApplicationsCommercial
MaterialPP,RUBBER
Bajrang Enviro Engineers
Hyderabad
Trusted Seller
Super Seller17 Years
Ready To Use Culture Media - Physical Form: Powder
Price: 1500 INR/Gram
MOQ500 g Gram/Grams
StorageRoom Temperature
Usagepharmaceutical industry, animal pharmaceutical sector, and biomedical fields.
Place of OriginIndia
Physical FormPowder
Shelf Life3 Years
TypeReady To Use Culture Media
View More

Readymed Culture Media - Color: White
Price : 2500 INR

Readymed Dehydrated Culture Media ( For Dignostic And Qc Testing) - Drug Type: General Medicines
Price : 2500 INR

Readymed Culture Media For Bio Fertilizers And Biopesticides - Grade: Technical Grade
Price : 2500 INR

ReadyMED Culture Media For Bio Fertilizers And Biopesticides
Price : 2500 INR
Prepared Culture Media
Suitable ForLaboratory and Diagnostics
FunctionSupports microbial growth
Storage CapacityRoom temperature or as specified
PropertiesReady-to-use culture media for microbial growth
ApplicationMicrobiology and Laboratory Use
UseCultivation of microorganisms
Growth Medium - Agar, 15mm Depth x 90mm Diameter, Sterile Petri Dish | Precise Control, Customizable, Reliable Bacterial Growth
MaterialAgar
Diameter90mm
Depth15mm
SterilitySterile
PackagingPetri dish
StorageRefrigerated
View More

Culture Media Ingredients
Price : 400 INR
Tubes Culture Media - Round & Flat Bottom Glass & Plastic Tubes, 5-100ml Capacities, Transparent Color, Laboratory Use
Price: 14 INR/Piece
MOQ1 Piece/Pieces
UsageChemical Laboratory
Product TypeTubes Culture
ColorTransparent
MaterialGlass And Plastic
Zoom Scientific World
Ambala
Trusted Seller
Premium Seller16 Years
Cell Culture Media Cas No: 6000-43-7
Price: /Kilograms
MOQ25 Kilograms/Kilograms
Purity99.9%
Storage InstructionsStore at 2-8AdegC, protect from light
UsageUsed in cell growth and maintenance
Physical StateLiquid
Size500 mL, 1 L, 5 L
Packaging TypeSterile plastic bottles or containers
Jeevan Chemicals & Pharmaceuticals
Navi Mumbai
Trusted Seller
Premium Seller21 Years
Macconkey Broth With Neutral Red
Price: 8000 INR/Piece
MOQ1 Piece/Pieces
Shelf Life2 Years
Packaging Type500 g
Ph Level7.0-7.4
Storage Instructions15-25 C
GradeMicrobiology
TypeOther, Broth Media
Sartorius Biopreservation Solutions - Dimension (L*W*H): 5.0*5.0*3.0 Centimeter (Cm)
Price: 14500 INR/Piece
MOQ1 Piece/Pieces
Dimension (L*W*H)5.0*5.0*3.0 Centimeter (cm)
Product TypeCold Storage Medium (NutriStor)
Weight0.12 kg Kilograms (kg)
Equipment TypeBiopreservation reagent (cryopreservation & cold storage)
Inorbvict Healthcare India Pvt. Ltd.
Pune
Trusted Seller
Premium Seller3 Years
SHEEP BLOOD DEFIBRINATED
Molecular WeightN/A (Mixture)
Physical FormLiquid
Molecular FormulaN/A (Mixture)
SmellOther, Mild, Characteristic
TasteOther , Characteristic
UsageLaboratory research, microbiology media
FAQs Related to Culture Media
DWTC Fog Treatment Culture
MOQ100 Pack/Packs
ApplicationOther, Odour & fog control in waste management and industrial applications
IngredientsSelective bacterial cultures, enzymes, stabilizers
PropertiesUsed for odour and mist control through specialised bacterial cultures
SolubilitySoluble in water
Ph Level6.5-8.5
Shelf Life1 Year
Red Sheep Blood
Product TypeBlood Agar
Physical StateLiquid
VolumeVarious
PackagingGlass Bottle
Storage Temperature4-8°C
Shelf LifeVariable
Listeria Enrichment Broth (Twin pack) M569
Price: 5245 INR/Kilograms
MOQ1 Kilograms/Kilograms
UsageEnrichment of Listeria
Size500 g
Shelf Life4 Years
Physical StatePowdered media
Storage Instructions2-8C
Packaging TypeHDPE bottle
Microbiological Culture Media - High-Quality Materials, User-Friendly Design | Enhanced Performance for Diverse Laboratory Applications
MaterialHigh quality
ApplicationLaboratory use
DurabilityLonger life
PriceEconomic
QualityHigh
PerformanceGood
View More

Microbiological Media
Get Best Deal

Dehydrated Media
Get Best Deal
HEKTOEN ENTERIC AGAR
MaterialAgar
Diameter150mm
Depth15mm
Weight50g
SterilitySterile
PackagingPetri dish
View More

Plant Tissue Culture Media
Get Best Deal

Microbiology Culture Media
Get Best Deal

Plant Tissue Culture Media
Get Best Deal
MacConkey Broth Culture Media
More details...Bacto Peptone (RDM-P-13)
Price: 1485 INR/Bottle
MOQ10 Bottle/Bottles
TypeIndustrial Lab Chemicals
SPERM PROCESSING MEDIA (CRYO-MAG2-CV)
Product TypeMedia Kit
Dominant ColorPurple
Volume17ml
ComponentsTwo solutions
Density Gradient80%
SterilitySterile
Scientific Lab Chemicals Culture Media Flat Bottom Tubes With Screw Cap And Liner- 5Ml
Price: 45 INR/Unit
MOQ1 Unit/Units
TypeScientific Lab Chemicals
Sperm Processing Kits For IUI
AmpoulesTwo
Density solution2ml
Washing solution5ml
Density80%
BufferHEPES
ComponentsAlbumin, antibiotics
Tubes Culture Media
Cap5-60 ml
OD16-25 mm
Length75-200 mm
MaterialNA
Cap typeScrew
Tube shapeRound
Lactose Ttc Agar Purity(%): 99.9%
MOQ1 Piece/Pieces
TypeIndustrial Lab Chemicals
Purity(%)99.9%
Culture media
MaterialAgar
VolumeVaried
PackagingBottles, tubes
SterilitySterile
PHSpecific
ExpiryIndicated
Sperm Freezing Media - Liquid, Laboratory Grade, Highly Pure | Ideal for Hospital and Laboratory Use in IUI and IVF Procedures
Price: 1652 INR/Pack
MOQ10 PACKS(EACH PACK 10x1ml) Pack/Packs
GradeLaboratory
TypeHospital Lab Chemicals
Purity(%)Highly
Laboratory Reagents - High Grade Purity, Liquid/Solid Form | Longer Service Life, Simple to Use, Ideal for Sample Testing
Product TypeLaboratory reagents
UsageSample testing
PurityHigh grade
PackagingVarious options
ApplicationPharmaceutical labs
FormLiquid/Solid
Sperm Processing Media - Liquid Reagent Grade Oligospermic Sample Solution, High Purity | Ideal for Hospital and Laboratory Use, Glass Ampule Packaging, Made in India
Price Trend: 4000.00 - 4750.00 INR/Pack
MOQ10 Pack/Packs
GradeReagent Grade
TypeHospital Lab Chemicals
Purity(%)High
Client Testimonials & Reviews

RameshRaja
ANAND SCIENTIFIC COMPANY
We have been a paid member of tradeindia.com for past 2 years. Our products got promoted at tradeindia portal as well as Google Promotion. We received relevant business inquiries from potential clients. We are looking for a long term relationship with tradeindia, and hope tradeindia provides best services in future also.

PankajShah
STERLING CHEMICALS
TradeIndia is a good marketing tool. We have been using it to get leads for our products as well as use it for sourcing products which we require.
Culture Media Price List
This Data was Last Updated on 2026-05-04
Culture Media Manufacturers | Suppliers in India
Company Name | Member Since |
|---|---|
Jeevan Chemicals & Pharmaceuticals Navi Mumbai, India | 21 Years |
Dynamicro Labs Pvt. Ltd. Dombivli, India | 20 Years |
Bajrang Enviro Engineers Hyderabad, India | 17 Years |
Chaitanya Agro Biotech Pvt. Ltd. Buldana, India | 17 Years |
New Alliance Fine Chem Private Limited Mumbai, India | 16 Years |
Zoom Scientific World Ambala, India | 16 Years |
Marine Hydrocolloids Kochi, India | 14 Years |
Sr Group Delhi, India | 11 Years |
Aayursh Lifesciences India Private Limited Kalyan, India | 9 Years |
Igneus Life Science Dombivli, India | 4 Years |
Upcoming Tradeshows
Biofuel Expo 2026
Thu, 04 Jun, 2026 - Sat, 06 Jun, 2026
Eco Sustain Expo 2026
Thu, 30 Jul, 2026 - Sat, 01 Aug, 2026
HNC Expo 2026
Mon, 15 Jun, 2026 - Wed, 17 Jun, 2026
Marine & Offshore Qatar (MOQ) 2026
Mon, 16 Nov, 2026 - Tue, 17 Nov, 2026
IDEC India 2026
Thu, 04 Jun, 2026 - Fri, 05 Jun, 2026
Bharat Solar & EV Expo 2026
Fri, 22 May, 2026 - Sun, 24 May, 2026
International Crop Science Conference and Exhibition 2026
Thu, 25 Jun, 2026 - Fri, 26 Jun, 2026
Green Energy India Expo 2026
Thu, 11 Jun, 2026 - Sat, 13 Jun, 2026
STEEL DAY 2026
Thu, 25 Jun, 2026 - Fri, 26 Jun, 2026
Vietnam Sport Show 2026
Thu, 13 Aug, 2026 - Sat, 15 Aug, 2026
Popular Categories
Popular Products
Human HairForklift TrucksServo Voltage StabilizerBasmati RiceBackhoe LoaderCarry Bag Making MachineDrum LifterElectric StackerScissor LiftsIndustrial Vibrating ScreenRotameterFlowmeterRotary Air CompressorIndustrial Eto SterilizerRice Packaging MachinesShredding MachineHammer MillAutomatic Labelling MachineDiesel ForkliftAerial Work PlatformStorage Rack SystemEpoxy ResinMild Steel BarStainless Steel SheetsStainless Steel StripsBag Filling MachinesAsphalt PlantsSlat ConveyorOintment PlantPlanetary MixersLadies KurtisLed LightsCctv CameraBall ValveAnti Cancer MedicineAir CompressorIncense SticksSolar LightsGoods LiftsVitrified TilesStainless Steel CoilsPvc PipesPvc Pipe FittingsUpvc PipesUpvc Ball ValvePipe Elbows